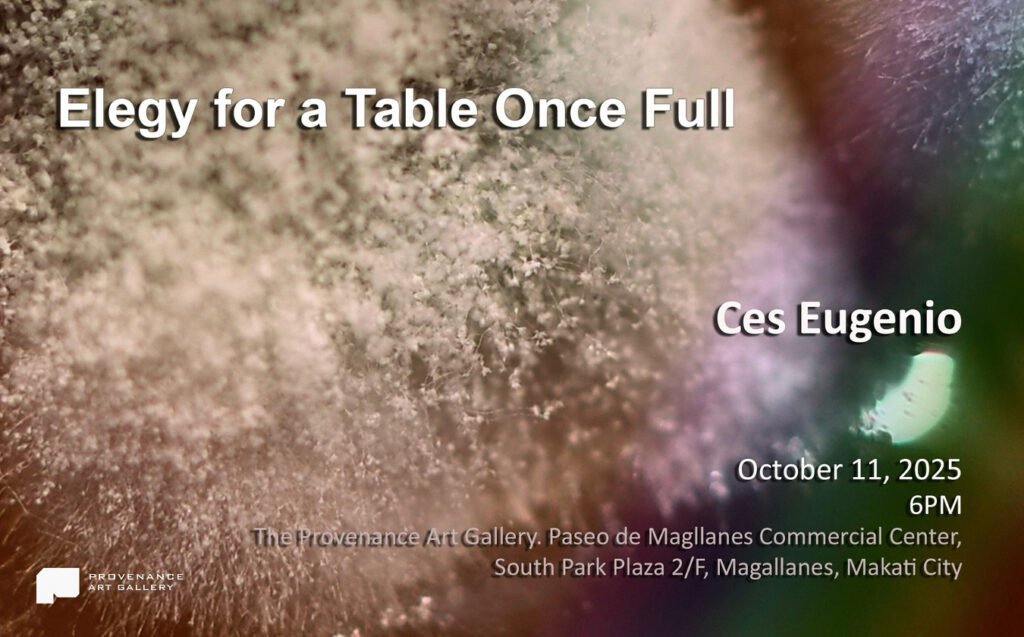

Elegy for a Table Once Full
By Ces Eugenio
In Elegy for a Table Once Full, Ces Eugenio reflects on what remains when appetite overshadows reverence. What began as a quiet study of decay—a banquet left untouched until molds bloomed and food soured—grew into a meditation on the ways we consume without thought, until even abundance collapses under the weight of excess.
A table once alive with celebration, now spoiled and forgotten, speaks not of hunger that sustains but of hunger that devours. Hunger driven by greed, by power, by the need to take more than enough. This same impulse echoes in how we strip the land of its resources, waste food without conscience, or discard lives for convenience. And yet, beneath these ruins, nature waits—
Patient.
Steady.
Reclaiming.
Molds, fungi, and the slow persistence of time become more than signs of decay. They are emblems of resilience, thriving where we abandon, reminding us that however much we build or destroy, the earth does not retaliate—it endures. Elegy for a Table Once Full is both mourning and mirror: a lament for what we allow to spoil, and a reckoning with what we lose when we forget our place in the rhythm of nature.
Do we disrespect the circle of life with our actions, or do we ravage it?
It is a summons to pause and ask, not only
What are we feeding?
But what are we starving when reverence is forgotten?
For the heart remembers.
The earth remembers.
And in the end, it is not the abundance that we leave behind,
but the silence of what we failed to honor.
To Ces Eugenio, this body of work is, in itself, a poem of mourning, but also a tribute, for what we overlooked to respect, and for what we continue to take for granted.
Written by Joanna Preysler Francisco